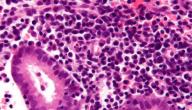
ما هي الأغشية المخاطية ما هي الأغشية المخاطية

محتويات
- ١ الفرق بين المذي والمني من حيث اللون
- ٢ الفرق بين المذي والمني من حيث القوام
- ٣ الفرق بين المذي والمني من حيث الرائحة
- ٤ الفرق بين المذي والمني من حيث حالة الجسم بعد النزول
- ٥ الفرق بين المذي والمني من حيث نجاسة وطهارة الأصل
- ٦ الفرق بين المذي والمني من حيث وقت الخروج
- ٧ الفرق بين المذي والمني من حيث الحكم المترتب على النزول
الفرق بين المذي والمني من حيث اللون
إنَّ لون المني أبيض غليظ عند الرجل، وأصفر رقيق عند المرأة،[١] بينما المذي يكون المذي عند الرجل ماء رقيق يشبه زلال البيض،[٢] وعند المرأة يكون أبيضَ لزجًا والله أعلم.[٣]
الفرق بين المذي والمني من حيث القوام
إنَ قوام المني لدى الرجال أنّه يكون غليظًا وسميكًا، بينما يكون عند النساء رقيق،[١] وأمّا المذي فيمتاز بقوامه الرقيق اللزج عند الرجال[٢] والنساء.[٣]
الفرق بين المذي والمني من حيث الرائحة
تختلف رائحة المني عن رائحة المذي، فرائحة المني قريبة من رائحة طلع النخيل أو رائحة العجين[٤] عند الرجال والنساء كما نصّ على ذلك بعض العلماء كالإمام النووي،[٥] أما رائحة المذي فلم يُذكر شيء بخصوص رائحته.[٦]
الفرق بين المذي والمني من حيث حالة الجسم بعد النزول
يخرج المني من جسدي المرأة والرجل حال الشهوة العارمة، فيخلّف خروجه هدوءًا وفتورًا في الجسم وانطفاءً في الشهوة، أمَّا خروج المذي فهو يخرج عند الشهوة الصغرى، ولا يعقبه فتور، بل إنّ الإنسان قد لا يشعر بخروجه، والله أعلم.[٧]
الفرق بين المذي والمني من حيث نجاسة وطهارة الأصل
اختلف فقهاء المذاهب الأربعة في طهارة المني والمذي أو نجاستهما، واستند كل مذهبٍ من تلك المذاهب على أدلةٍ مختلفة:
المني عند الشافعية
ذهب الشافعية إلى طهارة المني عند الرجل أو المرأة على حدٍّ سواء، واستندوا في ذلك الحكم على حديث عائشة -رضي الله عنها- أنَّها كانت تفرك المني عن ثوب رسول الله -صلى الله عليه وسلم- ثم يصلي فيه، ولمَّا سئل رسول الله -صلى الله عليه وسلم- عن المني أجاب فقال: "إنَّما هوَ بمنزلةِ البُصاقِ والمخاطِ، وإنَّما يَكْفيكَ أن تمسحُ بخرقةٍ أو بإذخِرٍ".[٨] الرقم الصحيح 1/327[٩]
وذاك يدل على طهارة المني، ولكنه يزال بأي كيفية؛ لأنه مستقذر كالبصاق والمخاط،[٩] وهناك قول عند الشافعية أنَّ مني المرأة نجس دونًا عن مني الرجل؛ وذلك مبنيّ على نجاسة رطوبة فرج المرأة، وللشافعية قولٌ أنَّ المني نجس سواء كان للرجل أم للمرأة، والله أعلى وأعلم.[١٠]
المني عند الحنفية
ذهب الحنفية إلى نجاسة المني، واستندوا إلى ذلك بحديث عائشة -رضي الله عنها- أنَّها قالت: "كُنْتُ أغْسِلُ الجَنَابَةَ مِن ثَوْبِ النبيِّ صَلَّى اللهُ عليه وسلَّمَ، فَيَخْرُجُ إلى الصَّلَاةِ، وإنَّ بُقَعَ المَاءِ في ثَوْبِهِ"،[١١] والحديث يدلّ دلالةً صريحةً على أنَّ عائشة -رضي الله عنها- قد غسلت المني عن ثوب رسول الله -صلى الله عليه وسلم- وقد علم بذلك وأقرها، ولم يعترضها ويخبرها بأنَّه طاهر، إذ إنَّه خارجٌ من أحد السبيلين كان شأنه شأن النجاسات.[١٠]
وقد سار على ذلك عدد من الصحابة والتابعين وممّا ورد عنهم أنَّ أبا هريرة -رضي الله عنه- عندما سئل عن المني فقال: إن رأيته فاغسله وإلا فاغسل الثوب كله، وكذلك روي عن التابعين أن المني بمنزلة البول.[١٠]
المني عند الحنابلة
اتفق الحنابلة في قولٍ لهم أنَّ المني نجسٌ واستدلوا بأدلة الحنفية في نجاسته،[١٢] ولهم قولٌ آخر -وهو المذهب عندهم- وافقوا به الشافعية أنَّ المني طاهر من الذكر والأنثى؛ مستندين على ما استند عليه الشافعية من أنّ أمّ المؤمنين كانت تفركه عن ثوب النبي عليه الصلاة والسلام.[١٠]
المني عند المالكية
ذهب المالكية إلى نجاسة المني متفقين مع بعض الأقوال لبعض المذاهب؛[١٣] معللين ذلك أنَّ المني هو دمٌ صار نَتنًا وفسادًا، وأيضًا هو يخرج من سبيل البول فألحقوه به طهارةً ونجاسةً يأخذ أحكامه كاملة، والله في ذلك جميعه هو أعلى وأعلم.[١٠]
المذي عند الشافعية
ذهب الشافعية إلى نجاسة المذي ونقضه للوضوء، وتكون إزالته كغيره من النجاسات بالاستنجاء بالماء أو الاستجمار بالحجر، لما ورد عن سهل بن حنيف: "كنتُ ألقَى مِنَ المذْيِ شدةً وعناءً، فكنتُ أُكْثِرُ منه الغسلَ. فذكرْتُ ذلِكَ لِرَسولِ اللهِ صلَّى اللهُ عليْهِ وسلَّمَ وسألتُهُ عنْهُ؟ فقال: إِنَّما يجزِئُكَ منْ ذلِكَ الوضوءُ فقلتُ يا رسولَ اللهِ، كيْفَ بما يُصِيبُ ثوبِي منْهُ؟ قال: يكفيكَ أنْ تأخُذَ كفًّا مِنْ ماءٍ فتنضَحَ بِهِ ثوبَكَ حيثُ ترَى أنَّهُ أصابَ مِنْهُ"،[١٤] فهو أشبهبالودي والله أعلم.[١٥]
المذي عند الحنفية
ذهب الحنفية إلى نجاسة المذي مستندين إلى حديث علي بن أبي طالب: "كُنتُ رجُلًا مَذَّاءً، فاستَحيَيْتُ أنْ أسأَلَ رسولَ اللهِ صلَّى اللهُ عليه وسلَّمَ من أجْلِ ابنتِه، فأمَرْتُ المِقدادَ، فسأَل رسولَ اللهِ صلَّى اللهُ عليه وسلَّمَ عنِ الرَّجُلِ يَجِدُ المَذْيَ، فقال: ذلك ماءُ الفَحْلِ، ولكلِّ فَحْلٍ ماءٌ، فلْيغسِلْ ذَكَرَه، وأُنثيَيْه، ولْيَتوضَّأْ وُضوءَه للصَّلاةِ"،[١٦] وأمذَا كيفية التطهر منه فاتفقوا بذلك مع الشافعية.[١٧]
المذي عند الحنابلة
ذهب الحنابلة إلى نجاسة المذي مستدلين على ذلك بأدلة الشافعية والحنفية، ولكن انفردوا بكيفية غسله فقالوا إنّه لا تجزئ إزالته بالحجر، ولا بدَّ من غسله بالماء ويجزئ غسله مرة واحدة.[١٨]
المذي عند المالكية
اتفق المالكية مع بقية الفقهاء في نجاسة المذي، ولكنَّهم انفردوا في كيفية الطهر منه، فقالوا لو خرج المذي من الرجل بلذة فإنّ الغسل واجب عليه، أمَّا لو لم يكن بلذة فيكفيه الحجر، إلّا إن كان فيه مرض يُخرج المذي منه كل يوم لو مرة واحدة فإنّه يُعفى عنه حينها.[مرجع]
الفرق بين المذي والمني من حيث وقت الخروج
يخرج المني عند اشتداد شهوة الإنسان بصورة دفقات متعددة، ولكنَّ المذي بخلاف المني يخرج عند فتور الشهوة ولا يخرج على دفقات مثل المني.[١٩]
الفرق بين المذي والمني من حيث الحكم المترتب على النزول
كما اختلف العلماء في نجاسة المني و طهارته فقد اختلفوا في كيفية التطهر من المذي، وكانت لهم أقوالُ في الحكم المترتب على نزول المني والمذي:
الحكم المترتب على نزول المني
ذهَبَ أكثر فقهاء المذاهب إلى أنَّ المني موجب للغسل عند الجمهور ولا يجزئ الوضوء منه لحديث رسول الله -صلى الله عليه وسلم- مع أم سليم أنها سألته: "إنَّ اللهَ لا يَسْتَحْيِي مِنَ الحَقِّ، هلْ علَى المَرْأَةِ مِن غُسْلٍ إذَا هي احْتَلَمَتْ؟ فَقالَ رَسولُ اللهِ صَلَّى اللهُ عليه وسلَّمَ: نَعَمْ إذَا رَأَتِ المَاءَ"،[٢٠] والله في ذلك على وأعلم.[٢١]
الحكم المترتب على نزول المذي
اتفقت المذاهب على أنَّ خروج المذي ينقض الوضوء، فشأنه شأن مفسدات الطهارة، وعليه فإنّه يجب الوضوء منه ولكن لا يجب الغسل لحديث علي بن أبي طالب -الذي سبق ذكره- أنَّ رجلًا من الصحابة سأل الرسول أنه كان يلاقي شدة من المذي فأمره عليه الصلاة والسلام بالوضوء.[١٨]
المراجع[+]
- ^ أ ب النسائي، السنن الكبرى، صفحة 221. بتصرّف.
- ^ أ ب أحمد مختار عمر، معجم اللغة العربية المعاصرة، صفحة 2081. بتصرّف.
- ^ أ ب مجموعة من المؤلفين، فتاوى الشبكة الإسلامية، صفحة 2773. بتصرّف.
- ↑ مجموعة من المؤلفين، فتاوى الشبكة الإسلامية، صفحة 2840. بتصرّف.
- ↑ النووي، شرح النووي على مسلم، صفحة 223. بتصرّف.
- ↑ الجويني، أبو المعالي، كتاب نهاية المطلب في دراية المذهب، صفحة 143. بتصرّف.
- ↑ "ما المقصود بالفتور بعد خروج المني"، إسلام ويب، اطّلع عليه بتاريخ 2020-11-18. بتصرّف.
- ↑ رواه الصنعاني، في العدة على الإحكام، عن عبد الله بن عباس، الصفحة أو الرقم:1، إسناده صحيح.
- ^ أ ب مجموعة من المؤلفين، كتاب الموسوعة الفقهية الكويتية، صفحة 142. بتصرّف.
- ^ أ ب ت ث ج مجموعة من المؤلفين، كتاب الموسوعة الفقهية الكويتية، صفحة 141. بتصرّف.
- ↑ رواه البخاري، في صحيح البخاري، عن عائشة أم المؤمنين، الصفحة أو الرقم:229، حديث صحيح.
- ↑ مجموعة من المؤافين، الموسوعة الفقهية الكويتية، صفحة 140. بتصرّف.
- ↑ مجموعة من المؤلفين، الموسوعة الفقهية الكويتية، صفحة 141. بتصرّف.
- ↑ رواه الترمذي، في سنن الترمذي، عن سهل بن حنيف، الصفحة أو الرقم:115، حديث حسن صحيح.
- ↑ مجموعة من المؤلفين، كتاب الموسوعة الفقهية الكويتية، صفحة 315. بتصرّف.
- ↑ رواه تخريج المسند، في شعيب الأرناؤوط، عن علي بن أبي طالب، الصفحة أو الرقم:1238، حديث حسن لغيره.
- ↑ مجموعة من المؤلفين، كتاب الموسوعة الفقهية الكويتية، صفحة 315. بتصرّف.
- ^ أ ب مجموعة من المؤلفين، كتاب الموسوعة الفقهية الكويتية، صفحة 316. بتصرّف.
- ↑ ابن عثيمين، كتاب مجموع فتاوى ورسائل العثيمين، صفحة 222. بتصرّف.
- ↑ رواه البخاري، في صحيح البخاري، عن أم سلمة أم المؤمنين، الصفحة أو الرقم:282، حديث صحيح.
- ↑ مجموعة من المؤلفين، كتاب الموسوعة الفقهية الكويتية، صفحة 142. بتصرّف.